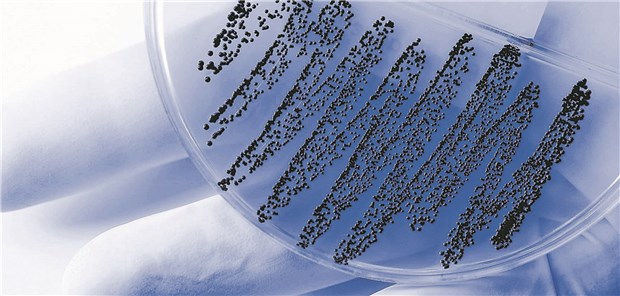

Europäisches Krankheitszentrum ECDC
Weiter Wissenslücken bei Antibiotika
Welcher Erreger macht sich beim Patienten breit? Wie steht es um seine Resistenzen?
© picprofi / stock.adobe.com
Stockholm. Beim Umgang mit Antibiotika gibt es laut einer neuen Befragung unter medizinischen Fachkräften in Europa weiter Wissenslücken. Generell sei das Wissen um und das Bewusstsein für die Probleme im Zusammenhang mit Antibiotika-Resistenzen unter Ärzten und dem weiteren Fachpersonal hoch, teilte das Europäische Zentrum für Krankheitsprävention und -kontrolle (ECDC) am Montag anlässlich des Europäischen Tags zur Sensibilisierung für Antibiotika mit.
Der Wissensstand der Befragten unterscheide sich aber abhängig von Land und Beruf teils erheblich. Deutschland landete bei der Befragung im oberen Mittelfeld.
Zuletzt hatte der Europäische Rechnungshof die EU zu einem stärkeren Einsatz gegen resistente Keime aufgefordert. Den Angaben zufolge sterben jedes Jahr rund 33.000 Menschen in der EU an Infektionen, die durch Antibiotika-resistente Bakterien verursacht wurden. Gegen solche Bakterien wirken die herkömmlichen Antibiotika nicht mehr.
Beim Kampf gegen resistente Keime spielten medizinische Fachkräfte eine fundamentale Rolle, erklärte ECDC-Direktorin Andrea Ammon. „Wir müssen sicherstellen, dass ihr Wissen über die Prävention und das Auftreten dieser Bedrohung auf dem neuesten Stand ist, damit sie entsprechend handeln und die Patienten korrekt informieren können.“
Bei der Untersuchung handelt es sich laut ECDC um die erste multinationale in der EU und des Europäischen Wirtschaftsraums, bei der Ärzte, Pharmazeuten, Krankenschwestern und andere Fachkräfte explizit zu ihrem Wissen rund um das Thema Antibiotika-Resistenz befragt wurden. Der überwiegende Teil der mehr als 18.000 Befragten (97 Prozent) konnte korrekt angeben, dass Antibiotika nicht gegen Erkältungen und Grippe wirken. Ein Viertel wusste hingegen nicht, dass eine Antibiotika-Behandlung das Risiko für eine Infektion mit einem resistenten Erreger erhöht.
Durchschnittlich den besten Wert bei der Beantwortung der Fragen erzielten die Befragten aus Irland, Kroatien, Frankreich und Litauen. Deutschland folgte auf Rang fünf. Am schlechtesten schnitten Lettland und Estland ab. (dpa)